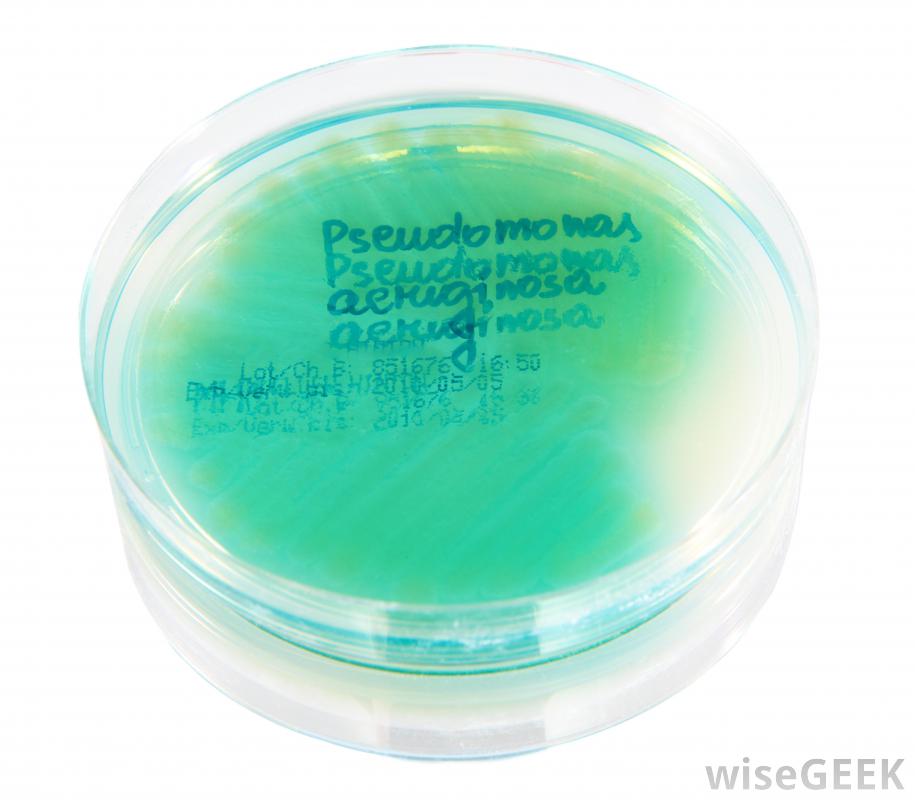

什么是假單胞菌(Pseudomonas Bacteria)?
假單胞菌是伽馬蛋白細菌中假單胞菌屬的任何一種細菌。這種細菌通常具有傳染性,并且與其他致病細菌有許多共同點。它們非常常見于水和某些植物種子中,因此,假單胞菌是一種桿狀的革蘭氏陰性菌假單胞菌是桿狀的,像許多其他的...
假單胞菌是伽馬蛋白細菌中假單胞菌屬的任何一種細菌。這種細菌通常具有傳染性,并且與其他致病細菌有許多共同點。它們非常常見于水和某些植物種子中,因此,假單胞菌是一種桿狀的革蘭氏陰性菌假單胞菌是桿狀的,像許多其他的細菌一樣,是革蘭氏陰性。這意味著當按照革蘭氏染色法用某種紫紅色染料染色時,它們在洗滌后不會保留染料的顏色,這一事實提供了有關這些細菌細胞壁結構的重要線索,表明它對某些類型的抗生素具有抗藥性,這一事實越來越重要 銅綠假單胞菌。銅綠假單胞菌是銅綠假單胞菌的一種,它負責醫院病人的感染,特別是那些患有癌癥或嚴重燒傷的病人。這種條件致病菌對營養的需求很低,這一點可以從它在蒸餾水中生長的事實來證明,它生長的首選溫度是986華氏度(37攝氏度),特別適合感染人體組織。但需要注意的是,這種細菌通常在健康人的皮膚和身體中發現無害。
銅綠假單胞菌。銅綠假單胞菌是銅綠假單胞菌的一種,它負責醫院病人的感染,特別是那些患有癌癥或嚴重燒傷的病人。這種條件致病菌對營養的需求很低,這一點可以從它在蒸餾水中生長的事實來證明,它生長的首選溫度是986華氏度(37攝氏度),特別適合感染人體組織。但需要注意的是,這種細菌通常在健康人的皮膚和身體中發現無害。 免疫系統受損的人應采取預防措施,防止假單胞菌的機會性感染一些種類的假單胞菌也是植物的致病菌。有趣的是,這些細菌中有很多只以某種方式感染某些植物,即使不是嚴格意義上的植物病原菌,這些細菌也會以其他方式影響農業,常常在蘑菇栽培中造成問題蘑菇栽培的問題。由于這些細菌的傳染性,它們實際上可以用來對抗其他農業病原體。自20世紀80年代以來,某些類型的假單胞菌,例如熒光假單胞菌(Pseudomonas fluorescens,Pseudomonas fluorescens)被直接應用于土壤和種子中,以防止作物病原菌的生長。這種用一種病原菌來阻止另一種病原菌生長的做法通常被稱為生防另一種具有生防特性的假單胞菌屬是綠綠假單胞菌,它本身產生一種抗生素,對攻擊植物的某些真菌有活性。在生物控制領域仍有許多研究要做,而且假單胞菌可能還具有其他有益的品質
免疫系統受損的人應采取預防措施,防止假單胞菌的機會性感染一些種類的假單胞菌也是植物的致病菌。有趣的是,這些細菌中有很多只以某種方式感染某些植物,即使不是嚴格意義上的植物病原菌,這些細菌也會以其他方式影響農業,常常在蘑菇栽培中造成問題蘑菇栽培的問題。由于這些細菌的傳染性,它們實際上可以用來對抗其他農業病原體。自20世紀80年代以來,某些類型的假單胞菌,例如熒光假單胞菌(Pseudomonas fluorescens,Pseudomonas fluorescens)被直接應用于土壤和種子中,以防止作物病原菌的生長。這種用一種病原菌來阻止另一種病原菌生長的做法通常被稱為生防另一種具有生防特性的假單胞菌屬是綠綠假單胞菌,它本身產生一種抗生素,對攻擊植物的某些真菌有活性。在生物控制領域仍有許多研究要做,而且假單胞菌可能還具有其他有益的品質 特殊敷料可用于嚴重燒傷患者,以促進愈合并防止假單胞菌感染。
特殊敷料可用于嚴重燒傷患者,以促進愈合并防止假單胞菌感染。
 銅綠假單胞菌。銅綠假單胞菌是銅綠假單胞菌的一種,它負責醫院病人的感染,特別是那些患有癌癥或嚴重燒傷的病人。這種條件致病菌對營養的需求很低,這一點可以從它在蒸餾水中生長的事實來證明,它生長的首選溫度是986華氏度(37攝氏度),特別適合感染人體組織。但需要注意的是,這種細菌通常在健康人的皮膚和身體中發現無害。
銅綠假單胞菌。銅綠假單胞菌是銅綠假單胞菌的一種,它負責醫院病人的感染,特別是那些患有癌癥或嚴重燒傷的病人。這種條件致病菌對營養的需求很低,這一點可以從它在蒸餾水中生長的事實來證明,它生長的首選溫度是986華氏度(37攝氏度),特別適合感染人體組織。但需要注意的是,這種細菌通常在健康人的皮膚和身體中發現無害。 免疫系統受損的人應采取預防措施,防止假單胞菌的機會性感染一些種類的假單胞菌也是植物的致病菌。有趣的是,這些細菌中有很多只以某種方式感染某些植物,即使不是嚴格意義上的植物病原菌,這些細菌也會以其他方式影響農業,常常在蘑菇栽培中造成問題蘑菇栽培的問題。由于這些細菌的傳染性,它們實際上可以用來對抗其他農業病原體。自20世紀80年代以來,某些類型的假單胞菌,例如熒光假單胞菌(Pseudomonas fluorescens,Pseudomonas fluorescens)被直接應用于土壤和種子中,以防止作物病原菌的生長。這種用一種病原菌來阻止另一種病原菌生長的做法通常被稱為生防另一種具有生防特性的假單胞菌屬是綠綠假單胞菌,它本身產生一種抗生素,對攻擊植物的某些真菌有活性。在生物控制領域仍有許多研究要做,而且假單胞菌可能還具有其他有益的品質
免疫系統受損的人應采取預防措施,防止假單胞菌的機會性感染一些種類的假單胞菌也是植物的致病菌。有趣的是,這些細菌中有很多只以某種方式感染某些植物,即使不是嚴格意義上的植物病原菌,這些細菌也會以其他方式影響農業,常常在蘑菇栽培中造成問題蘑菇栽培的問題。由于這些細菌的傳染性,它們實際上可以用來對抗其他農業病原體。自20世紀80年代以來,某些類型的假單胞菌,例如熒光假單胞菌(Pseudomonas fluorescens,Pseudomonas fluorescens)被直接應用于土壤和種子中,以防止作物病原菌的生長。這種用一種病原菌來阻止另一種病原菌生長的做法通常被稱為生防另一種具有生防特性的假單胞菌屬是綠綠假單胞菌,它本身產生一種抗生素,對攻擊植物的某些真菌有活性。在生物控制領域仍有許多研究要做,而且假單胞菌可能還具有其他有益的品質 特殊敷料可用于嚴重燒傷患者,以促進愈合并防止假單胞菌感染。
特殊敷料可用于嚴重燒傷患者,以促進愈合并防止假單胞菌感染。
- 發表于 2020-07-25 04:55
- 閱讀 ( 1291 )
- 分類:醫療衛生
你可能感興趣的文章
- 什么是纖維軟骨(Fibrocartilage)? 1435 瀏覽
- 月見草油對經前綜合癥有多有效(Effective Is Evening Primrose Oil for PMS)? 766 瀏覽
- 什么是中胚層(Mesoderm)? 2581 瀏覽
- 嬰兒脊椎按摩安全嗎(Is Infant Chiropractic Care Safe)? 928 瀏覽
- 難治期是什么(Refractory Period)? 794 瀏覽
- Lasix的副作用是什么(What Lasix® Side Effects)? 1421 瀏覽
- 什么是骨骼系統(Skeletal System)? 1009 瀏覽
- 什么是黃體酮藥片(Progesterone Pills)? 948 瀏覽
- 什么是體溫圖(Thermogram)? 766 瀏覽
- 剖腹產術后最好的性交技巧是什么(Best Tips for Intercourse After a C-Section)? 633 瀏覽
- 什么是口腔膿腫(Mouth Abscess)? 894 瀏覽
- 什么是靜脈移植(Vein Graft)? 770 瀏覽
- 什么是口腔醫學(Stomatology)? 854 瀏覽
- 催眠療法的好處是什么(Benefits of Hypnotherapy)? 683 瀏覽
- 什么是人乳頭瘤病毒(Human Papillomavirus)? 726 瀏覽
- 什么是小兒外傷護理(Pediatric Trauma Nursing)? 726 瀏覽
- 什么是心身疾病(Psychosomatic)? 806 瀏覽
- 最好的治療方法是什么(Best Cold Sore Treatment)? 886 瀏覽
- 什么是細胞毒素(Cytotoxin)? 1880 瀏覽
- 氣胸有哪些不同的治療方法(Different Types of Pneumothorax Treatment)? 612 瀏覽
- 什么是鼻導管(Nasal Tube)? 1269 瀏覽
- 什么是愈創木酚糖漿(Guaifenesin Syrup)? 993 瀏覽
- 什么是核心針活檢(Core Needle Biopsy)? 2266 瀏覽
- 什么是比薩科迪(Bisacodyl)? 914 瀏覽
- 什么是漿膜下纖維瘤(Subserosal Fibroid)? 693 瀏覽
- 什么是Masteron(Masteron)? 880 瀏覽
- 為什么我吃辣的時候流鼻涕(does my Nose Run When I Eat Spicy Food)? 862 瀏覽
- 什么是汗水小屋(Sweat Lodge)? 1117 瀏覽
- 什么是快速增長(Growth Spurt)? 1030 瀏覽
- 我怎樣治療肘關節脫位(Treat an Elbow Dislocation)? 716 瀏覽
相關問題
0 條評論
請先 登錄 后評論
admin
0 篇文章
作家榜 ?
-
 xiaonan123
189 文章
xiaonan123
189 文章
-
 湯依妹兒
97 文章
湯依妹兒
97 文章
-
 luogf229
46 文章
luogf229
46 文章
-
 jy02406749
45 文章
jy02406749
45 文章
-
 小凡
34 文章
小凡
34 文章
-
 Daisy萌
32 文章
Daisy萌
32 文章
-
 我的QQ3117863681
24 文章
我的QQ3117863681
24 文章
-
 華志健
23 文章
華志健
23 文章
推薦文章
- 什么是腋窩淋巴結病(Axillary Lymphadenopathy)?
- 我如何處理全身麻醉的副作用(Manage General Anesthesia Side Effects)?
- 什么是CPT編碼(CPT Coding)?
- 我怎樣才能止癢(Stop Itching)?
- 知覺的完形原理是什么(the Gestalt Principle of Perception)?
- 什么是神經康復(Neurorehabilitation)?
- 什么是肺囊腫(Pulmonary Cyst)?
- 孕期使用孕酮乳膏的利弊有哪些(Pros and Cons of Using Progesterone Cream in Pregnancy)?
- 什么是組織氣體(Tissue Gas)?
- 妊娠期蛋白尿的治療方法是什么(the Treatment for Proteinuria in Pregnancy)?
- 髓鞘疾病有哪些不同類型(Different Types of Myelin Disorders)?
- 帕羅西汀是什么(Paroxetine)?
- 運動機能學和生物力學有什么區別(the Difference between Kinesiology and Biomechanics)?
- 消融導管有哪些不同類型(Different Types of Ablation Catheters)?
- 成人學習障礙的癥狀是什么(Signs of a Learning Disability in Adults)?
- 什么是孔雀茶(Comfrey Tea)?
- 什么導致新生兒氣胸(What Causes Pneumothorax in Newborns)?
- 什么是均衡(Equipoise&Reg;)?
- 引起紅膿的常見原因是什么(Common Causes of Red Pus)?
- 針灸治療痛風有多有效(Effective Is Acupuncture for Gout)?
- 手上有什么過敏反應的跡象(Signs of an Allergic Reaction on the Hands)?
- 什么是代謝療法(Metabolic Therapy)?
- 什么是氮氣窒息(Nitrogen Asphyxiation)?
- 我怎樣才能去除手上的疣( Remove Hand Warts)?
- 什么是艾倫測驗(Allen's Test)?
- 回腸造口閉合如何(Care for an Ileostomy Closure)?
- 是什么導致了小水泡(What Causes Tiny Blisters)?
- 什么是無菌瓶(What Sterile Bottles)?
- 什么是臨終關懷運動(the Hospice Movement)?
- 什么是急性精神病學(Acute Psychiatry)?